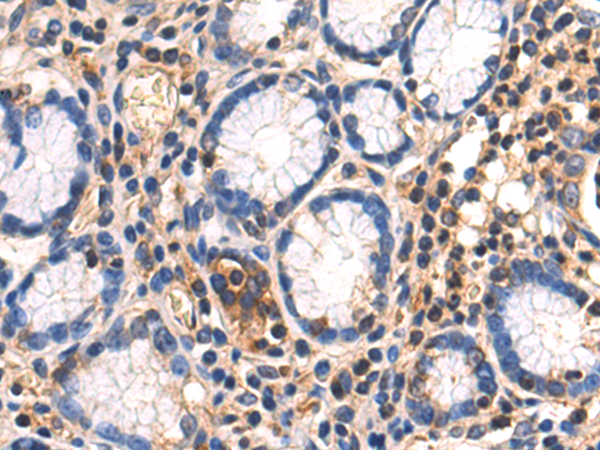

-
分类: 科研抗体货号: P06956别名: MAT, SAMS, MATA1, SAMS1应用: WB反应种属: Human, Mouse, Rat
-
分类: 科研抗体货号: P06955别名: CT1.4, MAGE-41, MAGE-X2, MAGE4, MAGE4A, MAGE4B, MGC21336应用: IHC反应种属: Human
-
分类: 科研抗体货号: P06975别名: ALDC, ALDH1, PUMB1, ALDH11, RALDH1, ALDH-E1; RALDH2, RALDH2-T, RALDH(II); ALDH6, RALDH3, ALDH1A6应用: WB,IHC反应种属: Human, Mouse
-
分类: 科研抗体货号: P06954别名: PEP-19应用: IHC反应种属: Human, Mouse, Rat
-
分类: 科研抗体货号: P06997别名: P53; BCC7; LFS1; BMFS5; TRP53应用: WB反应种属: Human
-
分类: 科研抗体货号: P06974别名: AKT; PKB; RAC; PRKBA; PKB-ALPHA; RAC-ALPHA应用: IHC反应种属: Human, Mouse, Rat
-
分类: 科研抗体货号: P06953别名: FLJ25987, MGC8385应用: WB,IHC反应种属: Human, Mouse, Rat
-
分类: 科研抗体货号: P06996别名: ARCI12应用: WB,IHC反应种属: Human
-
分类: 科研抗体货号: P06972别名: AG2, GOB-4, HAG-2, XAG-2, PDIA17应用: WB,IHC反应种属: Human, Mouse
-
分类: 科研抗体货号: P06952别名: APS, PSA应用: IHC反应种属: Human

鄂公网安备42018502007531号
鄂公网安备42018502007531号

